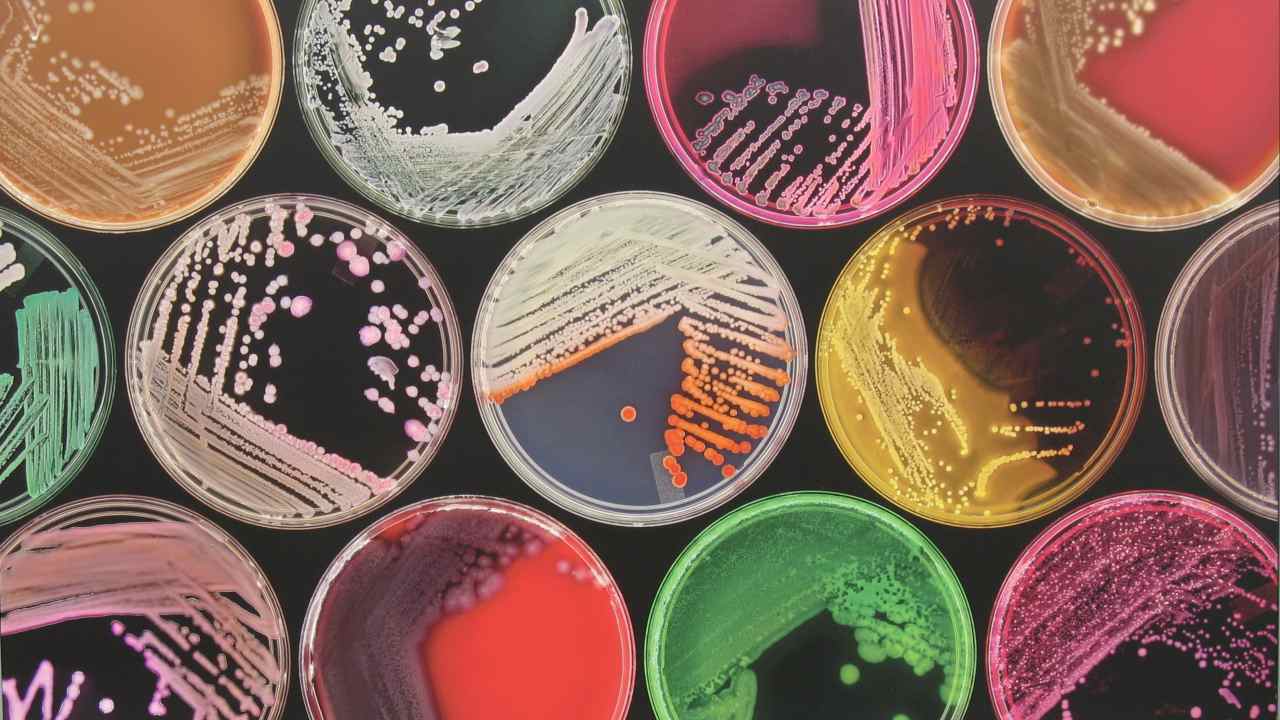
Breakthrough test for infections looks for all known harmful bacteria at once Breakthrough test for infections looks for all known harmful bacteria at once

Researchers at Columbia University’s School of Public Health have developed a breakthrough diagnostic test that can screen for all known harmful bacteria — including antibiotic-resistant bacteria in a single shot, a study
reported
. The ‘BacCapSeq’ platform is a collection of 4.2 million test sequences used to detect 307 known bacteria that cause infections in people. Each of these test sequences is designed to attach itself to a known DNA sequence on harmful bacteria. [caption id=“attachment_5221621” align=“alignnone” width=“1280”]
Representational image. Image courtesy: Geograph[/caption] These test sequence — once attached to the bacteria’s DNA — are “pulled out” from the test sample magnetically, and detected using the regular method of sequencing DNA on a large-scale. Currently, advanced diagnostic testing can pick up 19 different bacteria from samples using a technique called polymerase chain reaction (PCR), which multiplies undetectable levels of microbial DNA that can be picked up by a test. However, these tests are not effective where evasive bacteria or antimicrobial-resistance are at play. On average, 700,000 people die from antibiotic-resistant infections each year globally — most of them from developing countries, according to a
World Economic Forum report
. In pilot tests using blood samples with unknown bacterial strains, the test outperformed traditional testing in every case, including picking up on infections that current tests did not. “This platform is 1,000 times more sensitive than traditional unbiased testing, at a level comparable to tests that screen one bacterium at a time,” Dr Ian Lipkin, lead author at the Columbia Public Health,
said to
the university press. [caption id=“attachment_5436021” align=“alignnone” width=“1280”]
Reprentational image. Image courtesy: University of Bergen[/caption] Diagnosis of some infections like sepsis is time-consuming during critical hours when the infection could spread to dangerous levels. It takes between 48 and 72 hours to diagnose a sepsis infection, even after which tests may fail to pick up on evasive strains of bacteria. The newly developed BacSeqCap test takes 70 hours for a diagnosis in total, which researchers think could come down significantly with advancements in computing. “Microbiological intelligence must be an integral component of precision medicine… accurate, early differential diagnosis of infectious diseases and knowledge of drug sensitivity profiles will reduce mortality, morbidity and health care costs,” Lipkin
said
. BacCapSeq is a complement to VirCapSeq, a similar test developed to screen for all known human viral infections. The study was
published in
the journal mBio on 23 October.
)